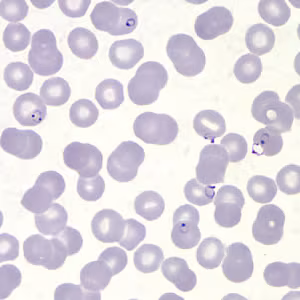

Case #153 – April, 2005
A 32-year-old male from Nigeria had been visiting some relatives in the United States for approximately a week. He went to a local emergency room for headaches, nausea, and general weakness and fatigue. Blood was drawn by fingerstick and thick and thin blood films were made. Images from the thick smears were captured and sent to CDC for confirmation. Figures A and B show what was seen on the Giemsa stained thick film when it was examined. What is your diagnosis? Based on what criteria? What additional steps would you recommend to achieve a definitive diagnosis?

Figure A

Figure B
Images presented in the DPDx case studies are from specimens submitted for diagnosis or archiving. On rare occasions, clinical histories given may be partly fictitious.
DPDx is an educational resource designed for health professionals and laboratory scientists. For an overview including prevention, control, and treatment visit www.cdc.gov/parasites/.